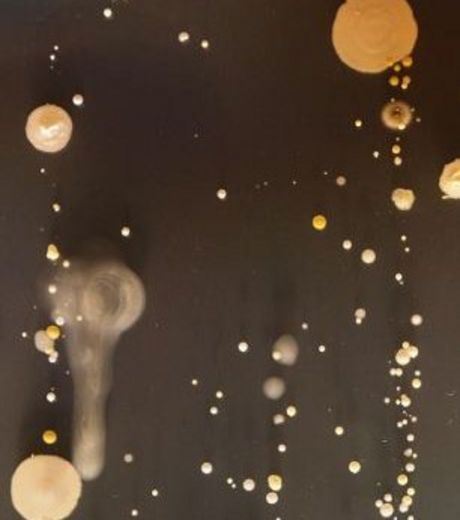
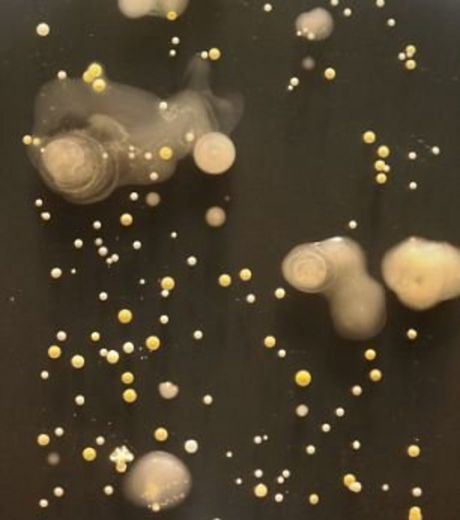
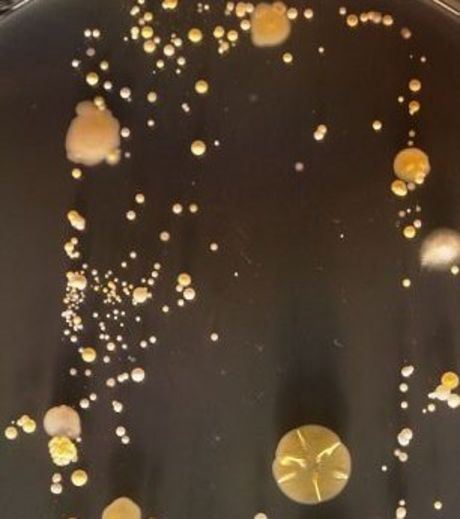

In England, a study has been conducted that confirms our smartphone is a medium of transmissions of bacteria. Students were able to observe many bacteria, harmless or not, on the smartphones screen.
Whenever, someone uses a smartphone whether it is for SMS or to make a call, it leaves a microbiological imprint on the phone. Students from University of Surrey printed the smartphones on the agar bacteria culture dishes to study the number and type of bacteria. They found that the nutritional media on the agar culture dish grew a number of bacteria. Although the majority of the bacteria are harmless, there were also some pathogens like Staphylococcus aureus which are present in the nasal passages and throats of 20% of the healthy individuals.
If insects, water, food, coughing, sneezing and sex are medium of bacterial transmission, our smartphones are too. In fact, the smartphone is predominantly a medium of the transmission for bacteria present close to the nose and throat.